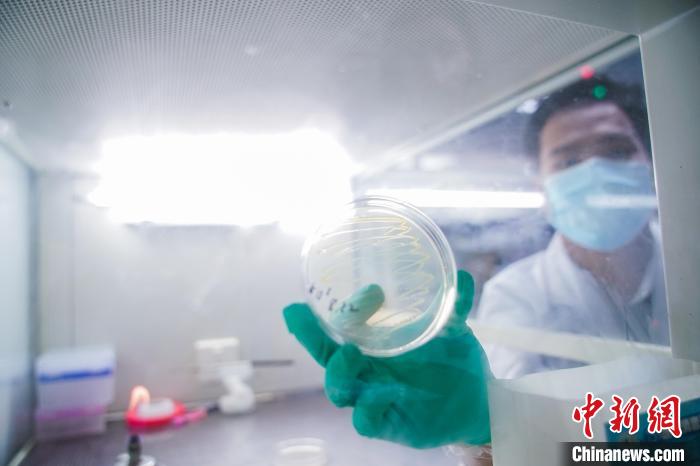

https://m.chinanews.com/wap/detail/chs/zw/9856674.shtml
圖為謝光杰在展示培養皿。 陳冠言 攝
中新網南寧9月20日電 (唐詩 陳冠言 黃艷梅)嫻熟地拆開培養皿,用棉球仔細清潔臺面后點上酒精燈,挑選土壤細菌進行后續研究……正在廣西大學求學的越南籍學生謝光杰開啟一天的實驗任務。
“越中兩國的糧食、水果資源都非常豐富,我希望能在農業領域有所作為,為兩國的農業交流與合作貢獻力量。”謝光杰在接受中新社記者采訪時說。
謝光杰本科就讀于越南國立農業大學,2017年在家人的支持下來到中國留學,其在廣西大學農學院獲得碩士學位后繼續攻讀博士學位。

圖為謝光杰在觀察甘蔗生長情況。 陳冠言 攝
初到廣西南寧市,謝光杰有些不習慣。除了飲食文化差異,學習中文也是“攔路虎”。在老師和同學的耐心幫助下,謝光杰逐漸適應了這里的生活。
廣西地處亞熱帶季風氣候區,是中國最大的蔗糖生產省區,廣西糖料蔗產量、食糖產量占全國總產量六成以上。謝光杰“因地制宜”,選擇甘蔗類基因、細菌作為研究方向。在5年多的時間里,謝光杰頻頻往返于甘蔗地和實驗室之間,參與了多個課題研究。
今年8月,謝光杰作為廣西大學的越南青年代表參加中國—東盟青年營活動。在為期6天的交流活動中,他與各國青年代表一同前往廣西柳州市,實地感受當地在農業發展、科技創新、生態環保等方面取得的成就。看到現代農業科技發展給中國農村地區帶來的變化,謝光杰更堅定了自己專研農學的信心。

圖為謝光杰在觀察甘蔗生長情況。 陳冠言 攝
自2004年中國—東盟博覽會在廣西南寧連續成功舉辦以來,廣西與東盟國家在各領域的交流合作愈加頻繁。謝光杰主動擔當起“文化橋梁”的角色,積極向親朋好友介紹中國發展現狀和中國文化。“我的妹妹正在越南高校讀本科,有機會的話我也想介紹她來中國留學。”
受新冠肺炎疫情影響,謝光杰自2020年起就未曾回越南。“每逢春節、中秋等節日,我都是和實驗室的老師同學一起過,很開心,很有歸屬感。”在謝光杰的微信朋友圈里,不乏與老師同學聚會的動態,照片中的他笑容燦爛,同學們一起在老師家下廚做飯的畫面,其樂融融。
對自己未來的發展,謝光杰做好了規劃:或是在中國繼續攻讀博士后,或是回到越南當一名老師。“我會深耕農學這一領域,擔當越中友好的使者,促進越中農業合作結出更多碩果。”謝光杰說。(完)